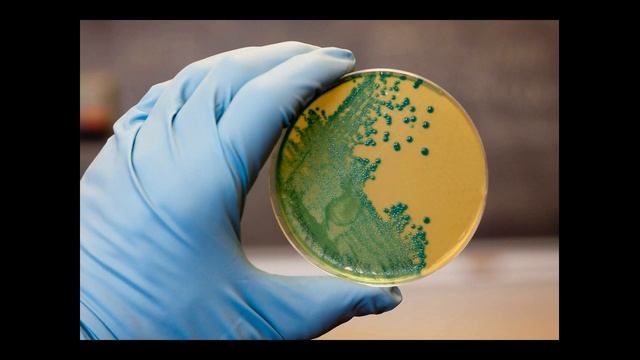
Листериоз – это инфекционное заболевание смотреть онлайн

Автор / Канал: Уборка в гармонии с природой Страница 4

LISTS OF LISTS TUTORIAL FOR NEWBIES | PYTHON | TIPS

моя подруга гигант 1сезон 3серия

Резинка для волос

Профопережение Демонстрация

Как добавить в Инстаграм более 5-ти аккаунтов. Как клонировать приложения.

24 октября 2023 г.

Samsung Galaxy S10 Instagram Mode Review - GAME CHANGER!

ПОСТАВЩИК БРЕНДОВЫХ СУМОК ПРЕМИАЛЬНОГО КАЧЕСТВА

Орехокол. Производство орехоколов, каллибраторов, вибросит.

How To Factory Reset Samsung Galaxy S21!

Как правильно поливать Авокадо

ИСТОРИЯ О SCRATCH CARD И КАК СЛИТЬ ВСЕ 1Х

Химчистка ковров Кристалл, г. Нижний Новгород

❗Первые ГРИБЫ ДЕКАБРЯ❄️❗ Рядовка Лиловоногая и Фламмулина в лесополосе❗ 3️⃣ декабря 2021 года❗

Восстановление фар или как не надо делать. Покрываю фары лаком

НОВЫЕ ТРЕБОВАНИЯ ЗАПАДА! Убрать ПАНЦИРЬ-С1 из War Thunder

Распаковка – Газовая варочная панель Maunfeld EGHG.64.63CW/G

Супер средство для очистки кожи и винила в действии

Интерьер из металла, изделие из профтрубы 20*20*1,5 мм., комплект в прихожую, своими руками.

Чистка колодца с. Батырево Батыревского района Чувашской Республики, 21.10.2017 г.

ТОП LOFT НОВИНКА Стол река из эпоксидной смолы !
Листериоз – это инфекционное заболевание

Защита фар пленкой как заклеить самому у дома гибридная пленка на фары сх5

Ручные отпариватели для одежды - CECOTEC SmoothForce 4000 UltraSteam и SmoothForce 2000 Smart
За каждым успешным каналом стоит личность, идея и сотни часов кропотливого труда. Если вы здесь, значит, автор «Уборка в гармонии с природой» уже сумел зацепить ваше внимание своим уникальным стилем или подачей. А мы на RUVIDEO позаботились о том, чтобы вы могли изучить весь архив его работ в максимально комфортных условиях — без лишней суеты и преград.
Почему за работами канала «Уборка в гармонии с природой» так интересно наблюдать? Всё просто: это честный контент, который находит отклик в сердцах зрителей. На нашем ресурсе вы можете смотреть онлайн все видео любимого автора бесплатно и в хорошем качестве. Нам важно, чтобы вы видели каждую деталь и слышали каждый нюанс, поэтому мы используем только стабильные плееры из открытых источников Rutube.
Следите за новинками канала, пересматривайте старые шедевры и открывайте для себя новые грани творчества «Уборка в гармонии с природой». Мы постоянно обновляем ленту, чтобы у вас под рукой всегда были самые свежие выпуски. Никаких сложных регистраций — только вы и творчество, которое вдохновляет. Приятного вам путешествия по миру авторского контента на RUVIDEO!
Видео взято из открытых источников Rutube. Если вы правообладатель, обратитесь к первоисточнику.